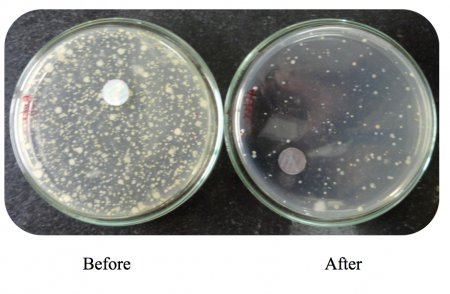
Bakterie před a po provedení Agnihotry

Vědecké aspekty Agnihotry I - vzduch
Čištění atmosféry pomocí Agnihotry / Dr. Ulrich Berk:
Hlavní poselství Homa terapie zní: Agnihotra čistí a léčí atmosféru - uzdravená atmosféra zase léčí životní prostředí, rostliny, zvířata a lidi. Jak se to dá pochopit z pohledu moderní vědy? Může výzkum takové prohlášení potvrdit nebo vyvrátit?

V následujících článcích se budeme zabývat různými aspekty Agnihotry – jejími účinky na naše životní prostředí (vzduch, půda a vodní zdroje), rostlinný svět včetně zemědělství a zahradnictví, zdraví a reprodukci zvířat, stejně tak na lidské zdraví.
Nejprve se podívejme, jakou roli hraje Agnihotra při čištění ovzduší. Může se rozlišovat mezi třemi různými druhy znečištění. Jedná se o biologické, chemické a fyzikální znečištění. Ve skutečnosti existuje ještě něco dalšího, čím je naše atmosféra znečištěná. Jedná se o znečištění myšlenkami. Ačkoli je to pravděpodobně ta nejhorší forma (protože vede k dalším druhům znečištění), budeme se tomuto aspektu věnovat později. Vědecké výzkumy v této oblasti jsou totiž velmi komplikované. Biologické znečištění ovzduší znamená přítomnost patogenních bakterií a virů v ovzduší. Může se prováděním Agnihotry takovému biologickému zamoření zabránit?
Některé studie tento předpoklad potvrdily. První z těchto studií se provedla v 80. letech na varšavské univerzitě v Polsku. Ukázalo se, že hned po začátku Agnihotry, se počet bakterií snížil. Již po 12 hodinách, tedy v okamžiku na další Agnihotru, jich z původního množství zbylo pouze 10%.
Bohužel k tomuto experimentu není žádá fotodokumentace, ale z následných experimentů již data a fotografie existují. Jeden takový se před několika lety provedl na Fergusson College (jedna z předních vysokých škol v Púně, Indie). Rozdíl před a po Agnihotře je zřejmý, ačkoli měření se provedlo jen v půlhodinovém odstupu.
Bylo by zajímavé tento efekt sledovat po 12 hodinách nebo při pravidelném provádění Agnihotry po celý týden nebo měsíc.
Chemické znečištění ovzduší se týká chemických složek, které jsou škodlivé pro naše zdraví. Díky moderním technologiím si bezpočet těchto složek našel cestu do našich domovů a mnohé z nich jsou potenciálně nebezpečné pro člověka.
Nedávno se na Vikram univerzitě v Ujjainu, M.P. a na univerzitě North Maharashtra v Jalgaon v Indii se v této oblasti uskutečnila řada experimentů. Rovněž se zde zkoumaly chemické složky SOx (oxid siřičitý) a NOx (oxid dusíku), které vznikají při jakémkoliv druhu spalování. Hodnoty jsou znepokojivě vysoké, zejména ve městech, kde jezdí mnoho aut se spalovacími motory. Ve studii se také měřilo fyzikální znečištění jako je např. znečištění (pevnými) prachovými částicemi.
Výsledky vypadají takto:
Kvalita vzduchu ve vnitřních prostorech
(hodnoty v μg/m3)
doba odběru vzorků: 30 min
|
datum |
čas |
|
SOx |
NOx |
RSPM |
SPM |
|
28/03/2016 |
5:15 - 5:45 |
před Agnihotrou |
7,9 |
27,3 |
105 |
69 |
|
28/03/2016 |
6:30 - 7:00 |
během Agnihotry |
6,2 |
23,7 |
75 |
63 |
|
28/03/2016 |
7:00 - 7:30 |
po Agnihotře |
8,3 |
29,1 |
152 |
83 |
|
29/03/2016 |
10:30 - 11:00 |
15 hod. po Agnihotře |
5,6 |
21,9 |
56 |
47 |
SOx: Oxid síry
NOx: Oxid dusíku
SPM: Polétavý prach, prachové částice (Suspended Particulate Matter)
RSPM: Prachové částice (Respirable Suspended Particulate Matter) s průměrem menším nebo rovným 10 μm, které se mohou dostat hluboko do našich dýchacích orgánů.
Vzorky se odebíraly přístrojem High Volume Air Sampler (vzorkovač pro velký objem vzduchu), který vzduch nejprve nasaje a pak ho přefiltruje. Podle velikosti filtru se v něm zachytí určité částice.
Ačkoliv okamžitě po Agnihotře hodnoty mírně vzrostou (což lze očekávat, protože oheň vytváří určité množství SOx a NOx, stejně jako kouř), časem všechny hodnoty výrazně klesly pod původní hodnotou před Agnihotrou. To znamená, že Agnihotra ze vzduchu vyčistila tyto chemické a fyzikální znečišťující látky. Pokusy se prováděly v době východu i západu slunce, aby se vyloučily vlivy a rozdíly mezi normálním dnem a nocí. Dalším krokem bude provádět tento experiment po dobu jednoho týdne, kdy se Agnihotra bude pravidelně praktikovat ráno a večer.
V dalším článku budeme diskutovat o tom, jak Agnihotra ovlivňuje naše vodní zdroje. Existuje totiž celá řada zajímavých výsledků z pokusů!
související články: Agnihotra a Homa terapie
překlad a zdroj fotografií: Jan Běhůnek DiS, homaterapie.cz









